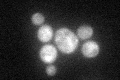
YLR017W

View description
Methylthioadenosine phosphorylase (MTAP), catalyzes the initial step in the methionine salvage pathway; affects polyamine biosynthesis through regulation of ornithine decarboxylase (Spe1p) activity; regulates ADH2 gene expression
Localization:
Intensity:
Fold change:
Significance:
-
C’ GFP library in SD
cytosol45.16 -
N' NOP1pr-GFP in SD

nucleus262.465 -
N' TEF2pr-mCherry in SD

cell periphery,vacuole0 -
N' NATIVEpr-GFP in SD

nucleus29.3178 -
N' TEF2pr-VC and Cyto-VN in SD

#N/A0 -
C’ GFP library in SD+DTT

cytosol35.330.78No -
C’ GFP library in SD+H2O2

cytosol37.550.83No -
C’ GFP library in Starvation Media

cytosol19.340.42No -
C’ GFP library on the background of Pup2-DaMP

cytosol -
C’ GFP library on the background of CCT mutant

cytosol54.7351.21197No
